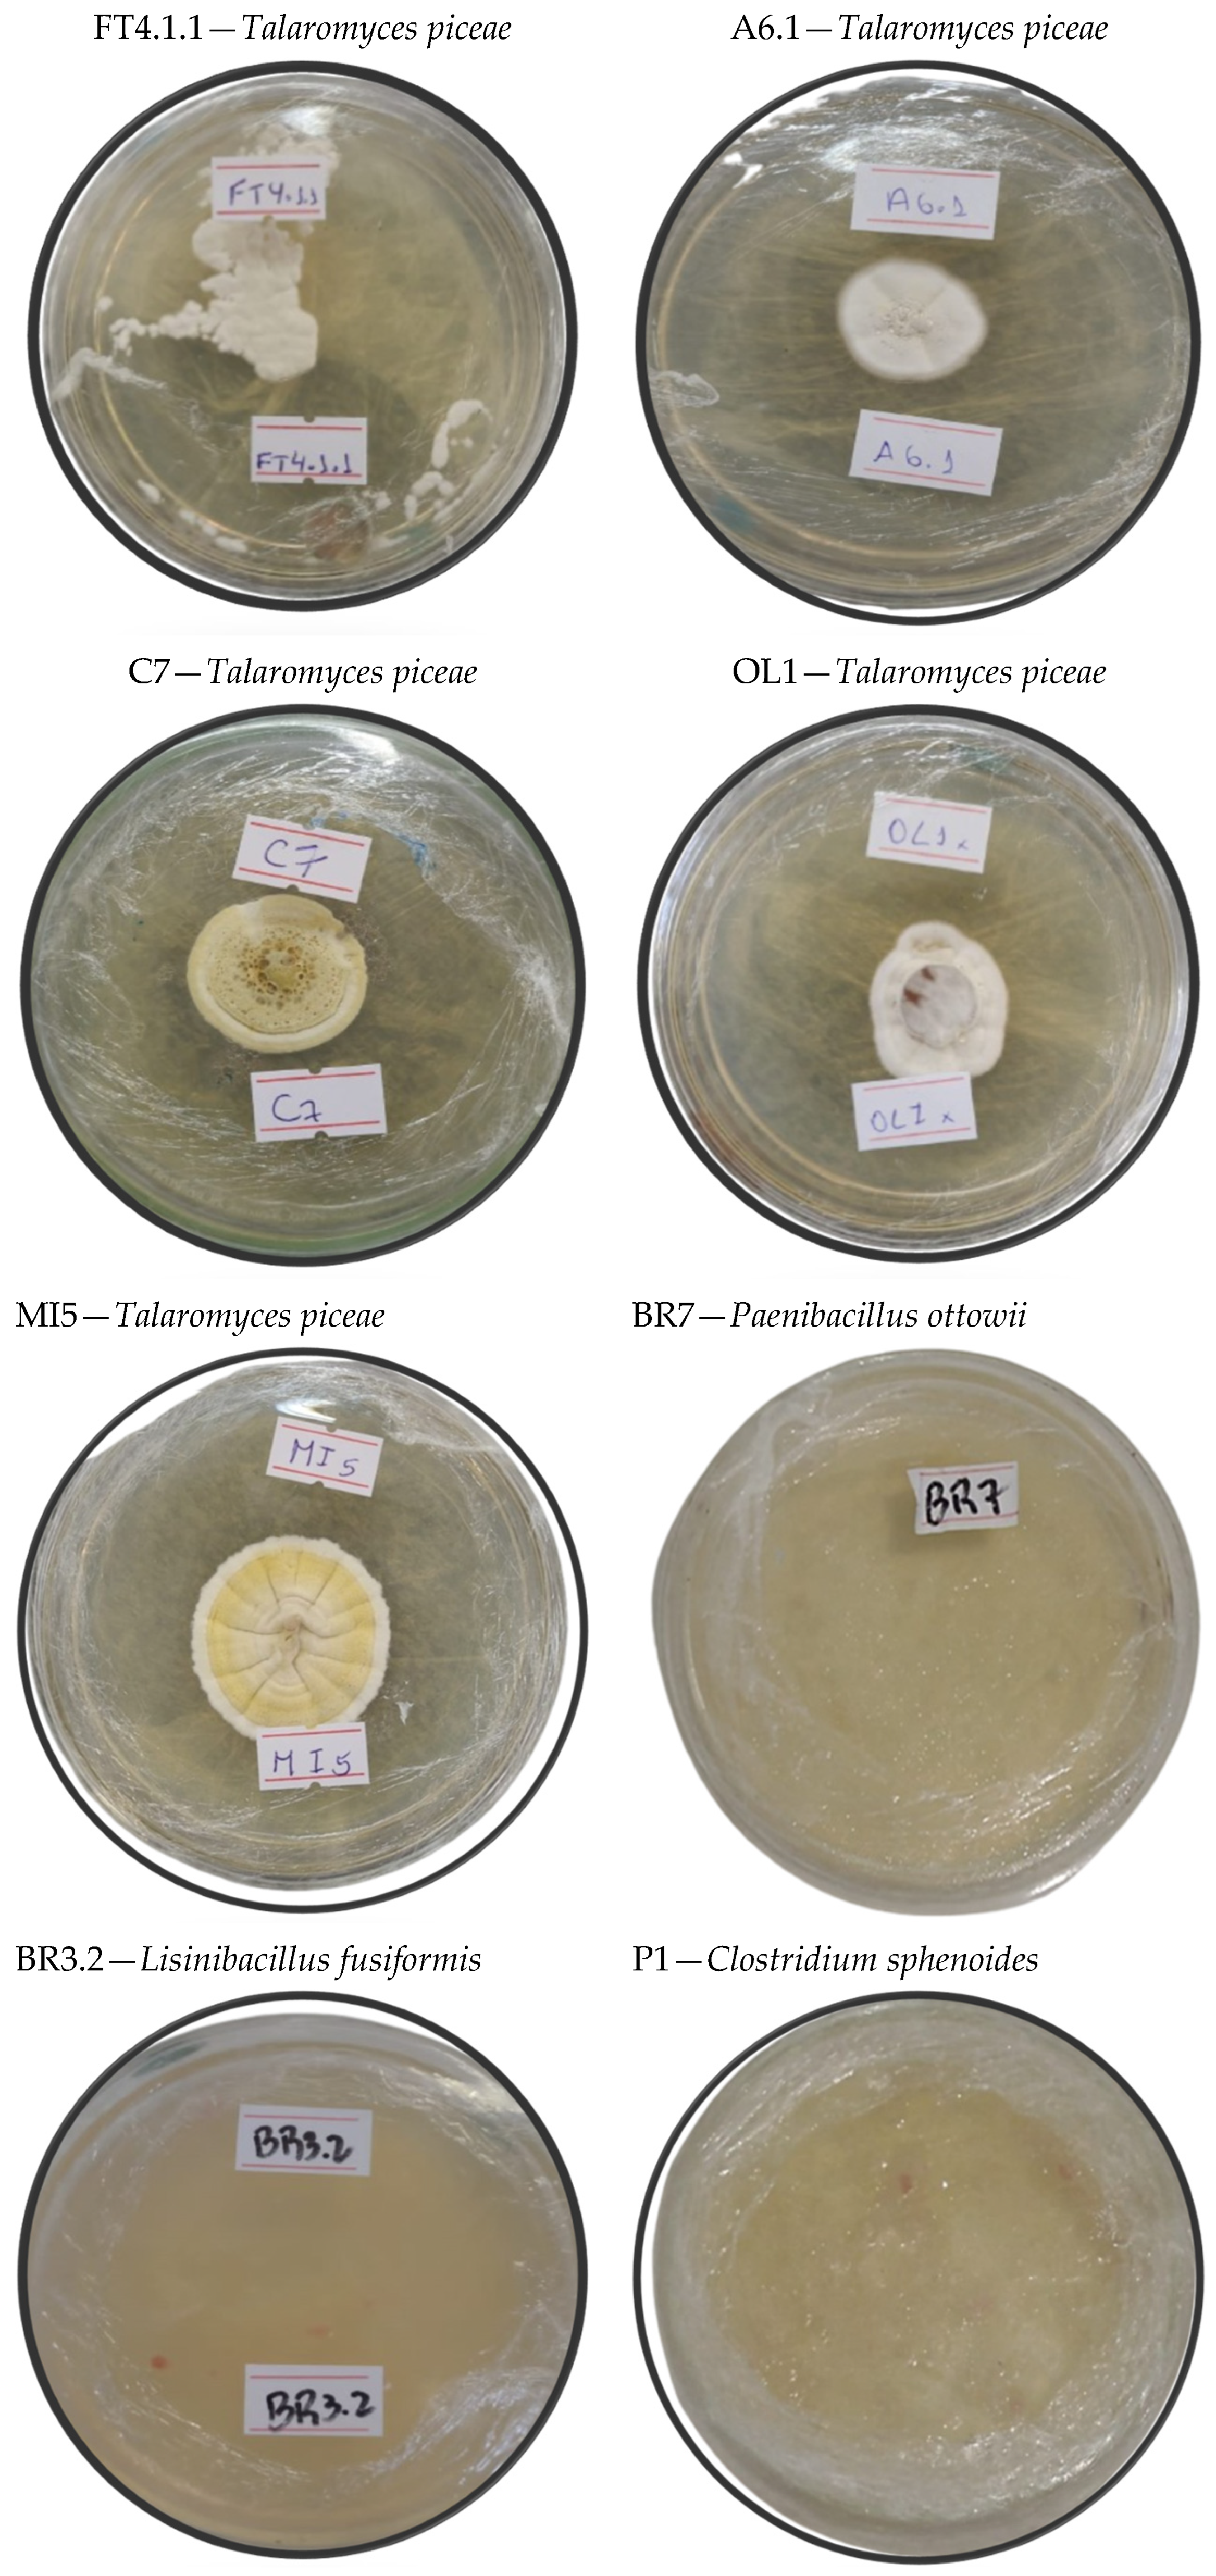

Neotropical Biodiversity as Microbial Frontline for Obtaining Bioactive Compounds with Potential Insecticidal Action
Abstract
1. Introduction
2. Materials and Methods
2.1. Sampling and Selection of Microorganisms
2.2. Isolation of Microorganisms
2.3. Submerged Fermentation
2.4. Application of Fermented Broth and Selection of Microorganisms
2.5. Lethal Concentrations
2.6. Analytical Procedure
Conidia Quantification
2.7. Identification of Microorganisms
2.8. Statistical Analysis
3. Results
3.1. Cultural and Phenotypic Characteristics of the Isolates
3.2. Selection of the Most Promising Isolates
3.3. Physicochemical Characteristics and PCA
3.4. Phylogenetic Tree
4. Discussion
5. Conclusions
Supplementary Materials
Author Contributions
Funding
Data Availability Statement
Conflicts of Interest
References
- Araújo, M.F.; Castanheira, E.M.S.; Sousa, S.F. The buzz on insecticides: A review of uses, molecular structures, targets, adverse effects, and alternatives. Molecules 2023, 28, 3641. [Google Scholar] [CrossRef] [PubMed]
- Malinga, L.N.; Laing, M.D. Efficacy of Biopesticides in the management of the cotton bollworm, Helicoverpa armigera (Noctuidae), under field conditions. Insects 2022, 13, 673. [Google Scholar] [CrossRef]
- dos Santos, M.S.N.; Ody, L.P.; Kerber, B.D.; Araujo, B.A.; Oro, C.E.D.; Wancura, J.H.C.; Mazutti, M.A.; Zabot, G.L.; Tres, M.V. New frontiers of soil fungal microbiome and its application for biotechnology in agriculture. World J. Microbiol. Biotechnol. 2023, 39, 287. [Google Scholar] [CrossRef] [PubMed]
- Verasoundarapandian, G.; Lim, Z.S.; Batrisyia, S.; Radziff, M.; Taufik, S.H.; Puasa, N.A.; Shaharuddin, N.A.; Merican, F.; Wong, C. Remediation of pesticides by microalgae as feasible approach in agriculture: Bibliometric strategies. Agronomy 2022, 12, 117. [Google Scholar] [CrossRef]
- Gullino, M.L.; Albajes, R.; Al-Jboory, I.; Angelotti, F.; Chakraborty, S.; Garrett, K.A.; Hurley, B.P.; Juroszek, P.; Lopian, R.; Makkouk, K.; et al. Climate change and pathways used by pests as challenges to plant health in agriculture and forestry. Sustainability 2022, 14, 12421. [Google Scholar] [CrossRef]
- Jaroslow, D.D.; Cunningham, J.P.; Smith, D.I.; Steinbauer, M.J. Seasonal phenology and climate associated feeding activity of introduced Marchalina Hellenica in Southeast Australia. Insects 2023, 14, 305. [Google Scholar] [CrossRef]
- Han, D.; Yoo, D.; Kim, T. Analysis of social welfare impact of crop pest and disease damages due to climate change: A case study of dried red peppers. Humanit. Soc. Sci. Commun. 2023, 10, 378. [Google Scholar] [CrossRef]
- Šunjka, D.; Mechora, Š. An alternative source of biopesticides and improvement in their formulation—Recent advances. Plants 2022, 11, 3172. [Google Scholar] [CrossRef]
- Carpane, P.D.; Llebaria, M.; Nascimento, A.F.; Vivan, L. Feeding injury of major lepidopteran soybean pests in South America. PLoS ONE 2022, 17, e0271084. [Google Scholar] [CrossRef]
- Marques, L.H.; Santos, A.C.; Castro, B.A.; Moscardini, V.F.; Rosseto, J.; Silva, O.A.B.N.; Babcock, J.M. Assessing the efficacy of Bacillus thuringiensis (Bt) pyramided proteins Cry1F, Cry1A.105, Cry2Ab2, and Vip3Aa20 expressed in Bt maize against lepidopteran pests in Brazil. J. Econ. Entomol. 2019, 112, 803–811. [Google Scholar] [CrossRef]
- De Groote, H.; Kimenju, S.C.; Munyua, B.; Palmas, S.; Kassie, M.; Bruce, A. Spread and impact of fall armyworm (Spodoptera frugiperda J.E. Smith) in maize production areas of Kenya. Agric. Ecosyst. Environ. 2020, 292, 106804. [Google Scholar] [CrossRef]
- Eschen, R.; Beale, T.; Bonnin, J.M.; Constantine, K.L.; Duah, S.; Finch, E.A.; Makale, F.; Nunda, W.; Ogunmodede, A.; Pratt, C.F.; et al. Towards estimating the economic cost of invasive alien species to African crop and livestock production. CABI Agric. Biosci. 2021, 2, 18. [Google Scholar] [CrossRef]
- Dorman, S.J.; Hopperstad, K.A.; Reich, B.J.; Kennedy, G.; Huseth, A.S. Soybeans as a non-Bt refuge for Helicoverpa zea in maize-cotton agroecosystems. Agric. Ecosyst. Environ. 2021, 322, 107642. [Google Scholar] [CrossRef]
- Kerns, D.D.; Yang, F.; Kerns, D.L.; Stewart, S.D.; Jurat-Fuentes, J.L. Reduced toxin binding associated with resistance to Vip3Aa in the corn earworm (Helicoverpa zea). Appl. Environ. Microbiol. 2023, 89, e01644-23. [Google Scholar] [CrossRef] [PubMed]
- Arnemann, J.A.; Roxburgh, S.; Walsh, T.; Guedes, J.; Gordon, K.; Smagghe, G.; Tay, W.T. Multiple incursion pathways for Helicoverpa armigera in Brazil show its genetic diversity spreading in a connected world. Sci. Rep. 2019, 9, 19380. [Google Scholar] [CrossRef] [PubMed]
- Aioub, A.A.A.; Ghosh, S.; AL-Farga, A.; Khan, A.N.; Bibi, R.; Elwakeel, A.M.; Nawaz, A.; Sherif, N.T.; Elmasry, S.A.; Ammar, E.E. Back to the origins: Biopesticides as promising alternatives to conventional agrochemicals. Eur. J. Plant Pathol. 2024, 169, 697–713. [Google Scholar] [CrossRef]
- Manson, S.; Campera, M.; Hedger, K.; Ahmad, N.; Adinda, E.; Nijman, V.; Budiadi, B.; Imron, M.A.; Lukmandaru, G.; Nekaris, K.A.I. The effectiveness of a biopesticide in the reduction of coffee berry borers in coffee plants. Crop Prot. 2022, 161, 106075. [Google Scholar] [CrossRef]
- Zhao, J.; Liang, D.; Li, W.; Yan, X.; Qiao, J.; Caiyin, Q. Research progress on the synthetic biology of botanical biopesticides. Bioengineering 2022, 9, 207. [Google Scholar] [CrossRef]
- Shahriari, M.; Zibaee, A.; Khodaparast, S.A.; Fazeli-Dinan, M. Screening and virulence of the entomopathogenic fungi associated with chilo suppressalis walker. J. Fungi 2021, 7, 34. [Google Scholar] [CrossRef]
- Wendel, J.; Cisneros, J.; Jaronski, S.; Vitek, C.; Ciomperlik, M.; Flores, D. Screening commercial entomopathogenic fungi for the management of Diaphorina citri populations in the Lower Rio Grande Valley, Texas, USA. BioControl 2022, 67, 225–235. [Google Scholar] [CrossRef]
- Lahlali, R.; Ezrari, S.; Radouane, N.; Kenfaoui, J.; Esmaeel, Q.; El Hamss, H.; Belabess, Z.; Barka, E.A. Biological Control of Plant Pathogens: A Global Perspective. Microorganisms 2022, 10, 596. [Google Scholar] [CrossRef]
- Sabbahi, R.; Hock, V.; Azzaoui, K.; Saoiabi, S.; Hammouti, B. A global perspective of entomopathogens as microbial biocontrol agents of insect pests. J. Agric. Food Res. 2022, 10, 100376. [Google Scholar] [CrossRef]
- Ayilara, M.S.; Adeleke, B.S.; Akinola, S.A.; Fayose, C.A.; Adeyemi, U.T.; Gbadegesin, L.A.; Omole, R.K.; Johnson, R.M.; Uthman, Q.O.; Babalola, O.O. Biopesticides as a promising alternative to synthetic pesticides: A case for microbial pesticides, phytopesticides, and nanobiopesticides. Front. Microbiol. 2023, 14, 1040901. [Google Scholar] [CrossRef] [PubMed]
- Afroz Toma, M.; Rahman, M.H.; Rahman, M.S.; Arif, M.; Nazir, K.H.M.N.H.; Dufossé, L. Fungal pigments: Carotenoids, riboflavin, and polyketides with diverse applications. J. Fungi 2023, 9, 454. [Google Scholar] [CrossRef] [PubMed]
- Amobonye, A.; Lalung, J.; Awasthi, M.K.; Pillai, S. Fungal mycelium as leather alternative: A sustainable biogenic material for the fashion industry. Sustain. Mater. Technol. 2023, 38, e00724. [Google Scholar] [CrossRef]
- Takahashi, J.A.; Barbosa, B.V.R.; Martins, B.d.A.; Guirlanda, C.P.; Moura, M.A.F. Use of the versatility of fungal metabolism to meet modern demands for healthy aging, functional foods, and sustainability. J. Fungi 2020, 6, 223. [Google Scholar] [CrossRef] [PubMed]
- Vaksmaa, A.; Guerrero-Cruz, S.; Ghosh, P.; Zeghal, E.; Hernando-Morales, V.; Niemann, H. Role of fungi in bioremediation of emerging pollutants. Front. Mar. Sci. 2023, 10, 1070905. [Google Scholar] [CrossRef]
- Damavandi, M.S.; Shojaei, H.; Esfahani, B.N. The anticancer and antibacterial potential of bioactive secondary metabolites derived from bacterial endophytes in association with Artemisia absinthium. Sci. Rep. 2023, 13, 18473. [Google Scholar] [CrossRef]
- Ghosh, S.; Rusyn, I.; Dmytruk, O.V.; Dmytruk, K.V.; Onyeaka, H.; Gryzenhout, M.; Gafforov, Y. Filamentous fungi for sustainable remediation of pharmaceutical compounds, heavy metal and oil hydrocarbons. Front. Bioeng. Biotechnol. 2023, 11, 1106973. [Google Scholar] [CrossRef] [PubMed]
- Mishra, B.; Mishra, A.K.; Kumar, S.; Mandal, S.K.; Lakshmayya, N.S.V.; Kumar, V.; Baek, K.H.; Mohanta, Y.K. Antifungal metabolites as food bio-preservative: Innovation, outlook, and challenges. Metabolites 2022, 12, 12. [Google Scholar] [CrossRef]
- Okal, E.J.; Heng, G.; Magige, E.A.; Khan, S.; Wu, S.; Ge, Z.; Zhang, T.; Mortimer, P.E.; Xu, J. Insights into the mechanisms involved in the fungal degradation of plastics. Ecotoxicol. Environ. Saf. 2023, 262, 115202. [Google Scholar] [CrossRef] [PubMed]
- Saye, L.M.G.; Navaratna, T.A.; Chong, J.P.J.; O’malley, M.A.; Theodorou, M.K.; Reilly, M. The anaerobic fungi: Challenges and opportunities for industrial lignocellulosic biofuel production. Microorganisms 2021, 9, 694. [Google Scholar] [CrossRef] [PubMed]
- Schein, D.; Santos, M.S.N.; Schmaltz, S.; Nicola, L.E.P.; Bianchin, C.F.; Ninaus, R.G.; de Menezes, B.B.; dos Santos, R.C.; Zabot, G.L.; Tres, M.V.; et al. Microbial prospection for bioherbicide production and evaluation of methodologies for maximizing phytotoxic activity. Processes 2022, 10, 2001. [Google Scholar] [CrossRef]
- Shankar, A.; Sharma, K.K. Fungal secondary metabolites in food and pharmaceuticals in the era of multi-omics. Appl. Microbiol. Biotechnol. 2022, 106, 3465–3488. [Google Scholar] [CrossRef] [PubMed]
- Srikanth, M.; Sandeep, T.S.R.S.; Sucharitha, K.; Godi, S. Biodegradation of plastic polymers by fungi: A brief review. Bioresour. Bioprocess. 2022, 9, 42. [Google Scholar] [CrossRef] [PubMed]
- Khan, R.A.A.; Najeeb, S.; Hussain, S.; Xie, B.; Li, Y. Bioactive secondary metabolites from Trichoderma spp. Against phytopathogenic fungi. Microorganisms 2020, 8, 817. [Google Scholar] [CrossRef] [PubMed]
- Velastegui-Montoya, A.; Montalván-Burbano, N.; Peña-Villacreses, G.; de Lima, A.; Herrera-Franco, G. Land use and land cover in tropical forest: Global research. Forests 2022, 13, 1709. [Google Scholar] [CrossRef]
- Menolli, N.; Sánchez-García, M. Brazilian fungal diversity represented by DNA markers generated over 20 years. Braz. J. Microbiol. 2020, 51, 729–749. [Google Scholar] [CrossRef] [PubMed]
- Hawksworth, D.L.; Lücking, R. Fungal diversity revisited: 2.2 to 3.8 million species. Fungal Kingd. 2017, 5, 79–95. [Google Scholar] [CrossRef]
- Wiens, J.J. How many species are there on Earth? Progress and problems. PLoS Biol. 2023, 21, 10–13. [Google Scholar] [CrossRef]
- Duden, A.S.; Verweij, P.A.; Faaij, A.P.C.; Baisero, D.; Rondinini, C.; Van Der Hilst, F. Biodiversity impacts of increased ethanol production in Brazil. Land 2020, 9, 12. [Google Scholar] [CrossRef]
- Valencia, E.Y.; Chambergo, F.S. Mini-review: Brazilian fungi diversity for biomass degradation. Fungal Genet. Biol. 2013, 60, 9–18. [Google Scholar] [CrossRef] [PubMed]
- Yao, H.; Sun, X.; He, C.; Maitra, P.; Li, X.; Guo, L. Phyllosphere epiphytic and endophytic fungal community and network structures differ in a tropical mangrove ecosystem. Microbiome 2019, 7, 57. [Google Scholar] [CrossRef] [PubMed]
- Crowther, T.W.; Van Den Hoogen, J.; Wan, J.; Mayes, M.A.; Keiser, A.D.; Mo, L.; Averill, C.; Maynard, D.S. The global soil community and its influence on biogeochemistry. Science 2019, 365, eaav0550. [Google Scholar] [CrossRef]
- Chalivendra, S. Microbial toxins in insect and nematode pest biocontrol. Int. J. Mol. Sci. 2021, 22, 7657. [Google Scholar] [CrossRef] [PubMed]
- Kumar, J.; Ramlal, A.; Mallick, D.; Mishra, V. An overview of some biopesticides and their importance in plant protection for commercial acceptance. Plants 2021, 10, 1185. [Google Scholar] [CrossRef] [PubMed]
- Negi, R.; Sharma, B.; Kaur, S.; Kaur, T.; Khan, S.S.; Kumar, S.; Ramniwas, S.; Rustagi, S.; Singh, S.; Rai, A.K.; et al. Microbial antagonists: Diversity, formulation and applications for management of pest–pathogens. Egypt. J. Biol. Pest Control 2023, 33, 105. [Google Scholar] [CrossRef]
- Portilla, M.; Jones, W.; Perera, O.; Seiter, N.; Greene, J.; Luttrell, R. Estimation of median lethal concentration of three isolates of Beauveria bassiana for control of Megacopta cribraria (heteroptera: Plataspidae) bioassayed on solid Lygus spp. Diet. Insects 2016, 7, 31. [Google Scholar] [CrossRef] [PubMed]
- Brun, T.; Rabuske, J.E.; Confortin, T.C.; Luft, L.; Todero, I.; Fischer, M.; Zabot, G.L.; Mazutti, M.A. Weed control by metabolites produced from Diaporthe schini. Environ. Technol. 2022, 43, 139–148. [Google Scholar] [CrossRef]
- Sharma, L.; Bohra, N.; Rajput, V.D.; Quiroz-Figueroa, F.R.; Singh, R.K.; Marques, G. Advances in entomopathogen isolation: A case of bacteria and fungi. Microorganisms 2021, 9, 16. [Google Scholar] [CrossRef]
- Todero, I.; Confortin, T.C.; Luft, L.; Brun, T.; Ugalde, G.A.; de Almeida, T.C.; Arnemann, J.A.; Zabot, G.L.; Mazutti, M.A. Formulation of a bioherbicide with metabolites from Phoma sp. Sci. Hortic. 2018, 241, 285–292. [Google Scholar] [CrossRef]
- de Souza, A.R.C.; Baldoni, D.B.; Lima, J.; Porto, V.; Marcuz, C.; Machado, C.; Ferraz, R.C.; Kuhn, R.C.; Jacques, R.J.; Guedes, J.V.; et al. Selection, isolation, and identification of fungi for bioherbicide production. Braz. J. Microbiol. 2017, 48, 101–108. [Google Scholar] [CrossRef] [PubMed]
- Abbott, W.S. The value of the dry substitutes for liquid lime. J. Econ. Entomol. 1925, 18, 265–267. [Google Scholar] [CrossRef]
- Jordan, C.; dos Santos, P.L.; Oliveira, L.R.d.S.; Domingues, M.M.; Gêa, B.C.C.; Ribeiro, M.F.; Mascarin, G.M.; Wilcken, C.F. Entomopathogenic fungi as the microbial frontline against the alien Eucalyptus pest Gonipterus platensis in Brazil. Sci. Rep. 2021, 11, 7233. [Google Scholar] [CrossRef] [PubMed]
- Greene, G.L.; Leppla, N.C.; Dickerson, W.A. Velvetbean caterpillar: A rearing procedure and artificial medium. J. Econ. Entomol. 1976, 69, 487–488. [Google Scholar] [CrossRef]
- Doyle, J.J.; Doyle, J.L. A rapid DNA isolation procedure for small quantities of fresh leaf tissue. Phytochem. Bull. 1987, 19, 11–15. [Google Scholar]
- Vilgalys, R.; Hester, M. Rapid genetic identification and mapping of enzymatically amplified ribosomal DNA from several Cryptococcus species. J. Bacteriol. 1990, 172, 4238–4246. [Google Scholar] [CrossRef]
- Aveskamp, M.M.; Verkley, G.J.M.; De Gruyter, J.; Murace, M.A.; Perelló, A.; Woudenberg, J.H.C.; Groenewald, J.Z.; Crous, P.W. DNA phylogeny reveals polyphyly of Phoma section Peyronellaea and multiple taxonomic novelties. Mycologia 2009, 101, 363–382. [Google Scholar] [CrossRef]
- Weisburg, W.G.; Barns, S.M.; Pelletier, D.A.; Lane, D.J. 16S ribosomal DNA amplification for phylogenetic study. J. Bacteriol. 1991, 173, 697–703. [Google Scholar] [CrossRef] [PubMed]
- Schmitz, A.; Riesner, D. Purification of nucleic acids by selective precipitation with polyethylene glycol 6000. Anal. Biochem. 2006, 354, 311–313. [Google Scholar] [CrossRef]
- Matsumura, A.T.S.; da Silva, M.E.; Grassotti, T.T.; Costa, L.d.F.X.; Matsumura, A.S. First report of Beauveria bassiana in the in vivo control of Eriosoma lanigerum in Brazilian apple trees. Rev. Ceres 2023, 70, 97–104. [Google Scholar] [CrossRef]
- Franzin, M.L.; Moreira, C.C.; da Silva, L.N.P.; Martins, E.F.; Fadini, M.A.M.; Pallini, A.; Elliot, S.L.; Venzon, M. Metarhizium associated with coffee seedling roots: Positive effects on plant growth and protection against Leucoptera coffeella. Agriculture 2022, 12, 2030. [Google Scholar] [CrossRef]
- Nascimento, V.C.; Rodrigues-Santos, K.C.; Carvalho-Alencar, K.L.; Castro, M.B.; Kruger, R.H.; Lopes, F.A.C. Trichoderma: Biological control efficiency and perspectives for the Brazilian Midwest states and Tocantins. Braz. J. Biol. 2022, 82, e260161. [Google Scholar] [CrossRef]
- Alves, E.B.; Casarin, N.F.B.; Gonçalves-Gervásio, R.d.C.; Omoto, C. Lime sulfur to control citrus flat mite and its interactions with the entomopathogenic fungus Lecanicillium muscarium. Arq. Inst. Biol. 2022, 89, e00232021. [Google Scholar] [CrossRef]
- Brites-Neto, J.; Maimone, N.M.; Piedade, S.M.D.S.; Andrino, F.G.; de Andrade, P.A.M.; de Assis Baroni, F.; Gomes, L.H.; de Lira, S.P. Scorpionicidal activity of secondary metabolites from Paecilomyces sp. CMAA1686 against Tityus serrulatus. J. Invertebr. Pathol. 2021, 179, 107541. [Google Scholar] [CrossRef]
- Pérez-González, O.; Gomez-Flores, R.; Tamez-Guerra, P. Insight into biological control potential of Hirsutella citriformis against Asian citrus psyllid as a vector of Citrus Huanglongbing disease in America. J. Fungi 2022, 8, 573. [Google Scholar] [CrossRef]
- Domingues, M.M.; Santos, P.L.; Gêa, B.C.C.; Carvalho, V.R.; Oliveira, F.N.; Soliman, E.P.; Silva, W.M.; Zanuncio, J.C.; Santos Junior, V.C.; Wilcken, C.F. Isolation and molecular characterization of Cordyceps sp. from Bemisia tabaci (Hemiptera: Aleyrodidae) and pathogenic to Glycaspis brimblecombei (Hemiptera: Aphalaridae). Braz. J. Biol. 2024, 84, e253028. [Google Scholar] [CrossRef]
- Homrahud, D.; Uraichuen, S.; Attathom, T. Cultivation of Aschersonia placenta Berkeley and Broom and its efficacy for controlling Parlatoria ziziphi (Lucas) (Hemiptera: Diaspididae). Agric. Nat. Resour. 2016, 50, 179–185. [Google Scholar] [CrossRef]
- Etchecopaz, A.; Toscanini, M.A.; Gisbert, A.; Mas, J.; Scarpa, M.; Iovannitti, C.A.; Bendezú, K.; Nusblat, A.D.; Iachini, R.; Cuestas, M.L. Sporothrix brasiliensis: A review of an emerging south american fungal pathogen, its related disease, presentation and spread in Argentina. J. Fungi 2021, 7, 170. [Google Scholar] [CrossRef]
- Mashtoly, T.A.; El-Beltagi, H.S.; Almujam, A.N.; Othman, M.N. The potential of a novel concept of an integrated bio and chemical formulate based on an entomopathogenic bacteria, Bacillus thuringiensis, and a chemical insecticide to control tomato leafminer, Tuta absoluta ‘(Meyrick)’ (Lepidoptera: Gelechiidae). Sustainability 2022, 14, 10582. [Google Scholar] [CrossRef]
- Chen, J.; Xu, Z.; Liu, Y.; Yang, F.; Guan, L.; Yang, J.; Li, J.; Niu, G.; Li, J.; Jin, L. Talaromyces sp. ethyl acetate crude extract as potential mosquitocide to control Culex pipiens quinquefasciatus. Molecules 2023, 28, 6642. [Google Scholar] [CrossRef] [PubMed]
- Nicoletti, R. Talaromyces–Insect Relationships. Microorganisms 2022, 10, 45. [Google Scholar] [CrossRef]
- Tian, Y.; Zhao, Y.; Fu, X.; Yu, C.; Gao, K.; Liu, H. Isolation and identification of Talaromyces sp. strain Q2 and its biocontrol mechanisms involved in the control of Fusarium wilt. Front. Microbiol. 2021, 12, 724842. [Google Scholar] [CrossRef]
- Raheja, Y.; Kaur, B.; Falco, M.; Tsang, A.; Chadha, B.S. Secretome analysis of Talaromyces emersonii reveals distinct CAZymes profile and enhanced cellulase production through response surface methodology. Ind. Crops Prod. 2020, 152, 112554. [Google Scholar] [CrossRef]
- Eski, A.; Demir, İ.; Güllü, M.; Demirbağ, Z. Biodiversity and pathogenicity of bacteria associated with the gut microbiota of beet armyworm, Spodoptera exigua Hübner (Lepidoptera: Noctuidae). Microb. Pathog. 2018, 121, 350–358. [Google Scholar] [CrossRef]
- Loulou, A.; Mastore, M.; Caramella, S.; Bhat, A.H.; Brivio, M.F.; Machado, R.A.R.; Kallel, S. Entomopathogenic potential of bacteria associated with soil-borne nematodes and insect immune responses to their infection. PLoS ONE 2023, 18, e0280675. [Google Scholar] [CrossRef]
- Passera, A.; Rossato, M.; Oliver, J.S.; Battelli, G.; Shahzad, G.I.R.; Cosentino, E.; Sage, J.M.; Toffolatti, S.L.; Lopatriello, G.; Davis, J.R.; et al. Characterization of Lysinibacillus fusiformis strain S4C11: In vitro, in planta, and in silico analyses reveal a plant-beneficial microbe. Microbiol. Res. 2021, 244, 126665. [Google Scholar] [CrossRef] [PubMed]
- Mohammad, Q.; Jamal, S. Lysinibacilli: A biological factories intended for diseases genus Lysinibacillus. J. Fungi 2022, 8, 1288. [Google Scholar]
- Grady, E.N.; MacDonald, J.; Liu, L.; Richman, A.; Yuan, Z.C. Current knowledge and perspectives of Paenibacillus: A review. Microb. Cell Fact. 2016, 15, 1–18. [Google Scholar] [CrossRef]
- Henriques, B.S.; Garcia, E.S.; Azambuja, P.; Genta, F.A. Determination of chitin content in insects: An alternate method based on calcofluor staining. Front. Physiol. 2020, 11, 117. [Google Scholar] [CrossRef]
- Bello, E.; Chen, Y.; Alleyne, M. Staying dry and clean: An insect’s guide to hydrophobicity. Insects 2023, 14, 42. [Google Scholar] [CrossRef]
- Rizza, M.A.; Wijayanti, W.; Hamidi, N.; Wardana, I.N.G. Role of intermolecular forces on the contact angle of vegetable oil droplets during the cooling process. Sci. World J. 2018, 2018, 5283753. [Google Scholar] [CrossRef] [PubMed]
- Chaves Neto, J.R.; Nascimento dos Santos, M.S.; Mazutti, M.A.; Zabot, G.L.; Tres, M.V. Phoma dimorpha phytotoxic activity potentialization for bioherbicide production. Biocatal. Agric. Biotechnol. 2021, 33, 101986. [Google Scholar] [CrossRef]
- Yong, J.; Yang, Q.; Hou, X.; Chen, F. Emerging separation applications of surface superwettability. Nanomaterials 2022, 12, 688. [Google Scholar] [CrossRef]

| Collection Location | State | Geographic Coordinates | Number of Microorganisms Collected | |
|---|---|---|---|---|
| Latitude | Longitude | |||
| Santa Maria | RS | −29.4129 | −53.4803 | 125 |
| Lavras do Sul | RS | −30.4857 | −53.5335 | 15 |
| Cerro Largo | RS | −28.1506 | −54.7686 | 9 |
| São Vicente do Sul | RS | −29.4132 | −54.4047 | 3 |
| Luziânia | GO | −16.2345 | −47.9167 | 11 |
| Microorganism | Identification | Classification | Collection Location | Concentration (Conidia mL−1) | Density (CFU) | Time (h) | Genre-Level Classification |
|---|---|---|---|---|---|---|---|
| 1 | FT4.1.1 | Fungi | Santa Maria, RS, Brazil | 1.27 × 108 | 585.0 ± 71.0 | 48 | Talaromyces sp. |
| 2 | BR3 | Fungi | Luziânia, GO, Brazil | 5.10 × 106 | 1098.3 ± 336.5 | 96 | Aspergillus sp. |
| 3 | BR2.1 | Fungi | Luziânia, GO, Brazil | 3.00 × 108 | 922.6 ± 79.5 | 96 | Aspergillus sp. |
| 4 | MI2 | Fungi | Santa Maria, RS, Brazil | 2.30 × 106 | 127.0 ± 12.1 | 96 | Fusarium sp. |
| 5 | MI5 | Fungi | Santa Maria, RS, Brazil | 3.30 × 108 | 466.0 ± 0.0 | 72 | Talaromyces sp. |
| 6 | SH | Fungi | Santa Maria, RS, Brazil | 7.13 × 107 | 522.6 ± 147.0 | 96 | Penicillium sp. |
| 7 | MI3F2 | Fungi | Santa Maria, RS, Brazil | 3.20 × 108 | 612.3 ± 24.6 | 72 | Fusarium sp. |
| 8 | TR3.1 | Fungi | Santa Maria, RS, Brazil | 1.00 × 107 | 19.6 ± 7.3 | 96 | Fusarium sp. |
| 9 | C7 | Fungi | Santa Maria, RS, Brazil | 1.05 × 107 | 206.0 ± 27.0 | 120 | Talaromyces sp. |
| 10 | BR5.4 | Fungi | Luziânia, GO, Brazil | 3.30 × 107 | 214.6 ± 28.3 | 96 | Fusarium sp. |
| 11 | C9 | Fungi | Santa Maria, RS, Brazil | 7.00 × 108 | 231.6 ± 88.6 | 96 | Fusarium sp. |
| 12 | MI7 | Fungi | Santa Maria, RS, Brazil | 1.96 × 108 | 1194.0 ± 212.6 | 96 | Pythium sp. |
| 13 | OL1 | Fungi | Santa Maria, RS, Brazil | 1.40 × 107 | 81.6 ± 6.6 | 72 | Talaromyces sp. |
| 14 | CL4 | Fungi | Cerro Largo, RS, Brazil | 2.73 × 108 | 2.3 ± 1.3 | 48 | Trichoderma sp. |
| 15 | A6.1 | Fungi | Santa Maria, RS, Brazil | 2.10 × 107 | 3.0 ± 1.0 | 96 | Talaromyces sp. |
| 16 | MI3 | Fungi | Santa Maria, RS, Brazil | 6.00 × 108 | 42.0 ± 5.6 | 96 | Fusarium sp. |
| 17 | LV4 | Fungi | Lavras do Sul, RS, Brazil | 3.70 × 102 | 395.6 ± 88.5 | 96 | Trichoderma sp. |
| 18 | MIA | Fungi | Santa Maria, RS, Brazil | 7.10 × 107 | 267.0 ± 76.2 | 96 | Botryoderma sp. |
| 19 | SN5 | Fungi | Santa Maria, RS, Brazil | 2.40 × 108 | 31.6 ± 4.0 | 48 | Fusarium sp. |
| 20 | LV1 | Fungi | Lavras do Sul, RS, Brazil | 4.00 × 108 | 138.5 ± 44.5 | 96 | Trichoderma sp. |
| 21 | CL2 | Fungi | Cerro Largo, RS, Brazil | 6.10 × 108 | 200.0 ± 15.5 | 96 | Pythium sp. |
| 22 | BR4.1 | Fungi | Luziânia, GO, Brazil | 1.75 × 108 | 45.6 ± 23.0 | 96 | Nigrospora sp. |
| 23 | MI6 | Fungi | Santa Maria, RS, Brazil | 3.40 × 108 | 155.30 ± 71.60 | 96 | Aspergillus sp. |
| 24 | CL3 | Fungi | Cerro Largo, RS, Brazil | 1.00 × 108 | 13.00 ± 1.70 | 96 | Trichoderma sp. |
| 25 | OL4 | Fungi | Santa Maria, RS, Brazil | 2.10 × 108 | 271.00 ± 143.10 | 96 | Rhizoctonia sp. |
| 26 | MA8 | Fungi | Santa Maria, RS, Brazil | 2.00 × 108 | 674.30 ± 169.10 | 96 | Pythium sp. |
| 27 | FT4.1F | Fungi | Santa Maria, RS, Brazil | 1.71 × 108 | 118.00 ± 20.60 | 48 | Nigrospora sp. |
| 28 | LV12 | Fungi | Lavras do Sul, RS, Brazil | 1.90 × 107 | 2.00 ± 0.00 | 96 | Trichoderma sp. |
| 29 | LV7 | Fungi | Lavras do Sul, RS, Brazil | 2.30 × 108 | 1420.50 ± 47.30 | 96 | Penicillium sp. |
| 30 | MI7F2 | Fungi | Santa Maria, RS, Brazil | 1.05 × 108 | 154.60 ± 47.50 | 96 | Penicillium sp. |
| 31 | CL12 | Fungi | Cerro Largo, RS, Brazil | 3.50 × 108 | 2.00 ± 0.00 | 120 | Trichoderma sp. |
| 32 | SN4 | Fungi | Santa Maria, RS, Brazil | 5.77 × 108 | 584.00 ± 191.10 | 96 | Fusarium sp. |
| 33 | MI5F1 | Fungi | Santa Maria, RS, Brazil | 3.30 × 108 | 466.00 ± 0.00 | 72 | Trichoderma sp. |
| 34 | CL7 | Fungi | Cerro Largo, RS, Brazil | 7.60 × 108 | 571.00 ± 87.60 | 96 | Trichoderma sp. |
| 35 | SN9 | Fungi | Santa Maria, RS, Brazil | 4.33 × 107 | 31.30 ± 5.50 | 96 | Fusarium sp. |
| 36 | MI2.2 | Fungi | Santa Maria, RS, Brazil | 3.40 × 107 | 37.20 ± 5.50 | 96 | Fusarium sp. |
| 37 | P1 | Bacteria | Santa Maria, RS, Brazil | - | 620.00 ± 0.00 | 96 | - |
| 38 | CBM | Bacteria | Santa Maria, RS, Brazil | - | 3.60 ± 3.00 | 120 | - |
| 39 | X1 | Bacteria | Santa Maria, RS, Brazil | - | 290.60 ± 22.50 | 72 | - |
| 40 | MID | Bacteria | Santa Maria, RS, Brazil | - | 1109.60 ± 197.40 | 96 | - |
| 41 | UMB1 | Bacteria | São Vicente do Sul, RS, Brazil | - | 866.30 ± 106.80 | 96 | - |
| 42 | C1 | Bacteria | Santa Maria, RS, Brazil | - | 550.00 ± 86.20 | 48 | - |
| 43 | LV19 | Bacteria | Lavras do Sul, RS, Brazil | - | 61.00 ± 4.30 | 96 | - |
| 44 | UMB2 | Bacteria | São Vicente do Sul, RS, Brazil | - | 474.00 ± 80.90 | 48 | - |
| 45 | OL5 | Bacteria | Santa Maria, RS, Brazil | - | 138.50 ± 44.50 | 96 | - |
| 46 | FTG | Bacteria | Santa Maria, RS, Brazil | - | 31.30 ± 5.50 | 96 | - |
| 47 | BR7 | Bacteria | Luziânia, GO, Brazil | - | 51.00 ± 31.90 | 96 | - |
| 48 | UMB6 | Bacteria | São Vicente do Sul, RS, Brazil | - | 138.50 ± 44.50 | 48 | - |
| 49 | BR3.2 | Bacteria | Luziânia, GO, Brazil | - | 77.60 ± 25.50 | 48 | - |
| 50 | A8 | Bacteria | Santa Maria, RS, Brazil | - | 10.60 ± 0.50 | 96 | - |
Disclaimer/Publisher’s Note: The statements, opinions and data contained in all publications are solely those of the individual author(s) and contributor(s) and not of MDPI and/or the editor(s). MDPI and/or the editor(s) disclaim responsibility for any injury to people or property resulting from any ideas, methods, instructions or products referred to in the content. |
© 2024 by the authors. Licensee MDPI, Basel, Switzerland. This article is an open access article distributed under the terms and conditions of the Creative Commons Attribution (CC BY) license (https://creativecommons.org/licenses/by/4.0/).
Share and Cite
Santos, M.S.N.; Ody, L.P.; Kerber, B.D.; Castro, I.A.; de Villa, B.; Ugalde, G.A.; Guedes, J.V.C.; Mazutti, M.A.; Zabot, G.L.; Tres, M.V. Neotropical Biodiversity as Microbial Frontline for Obtaining Bioactive Compounds with Potential Insecticidal Action. Processes 2024, 12, 1722. https://doi.org/10.3390/pr12081722
Santos MSN, Ody LP, Kerber BD, Castro IA, de Villa B, Ugalde GA, Guedes JVC, Mazutti MA, Zabot GL, Tres MV. Neotropical Biodiversity as Microbial Frontline for Obtaining Bioactive Compounds with Potential Insecticidal Action. Processes. 2024; 12(8):1722. https://doi.org/10.3390/pr12081722
Chicago/Turabian StyleSantos, Maicon S. N., Lissara P. Ody, Bruno D. Kerber, Isac A. Castro, Bruna de Villa, Gustavo A. Ugalde, Jerson V. C. Guedes, Marcio A. Mazutti, Giovani L. Zabot, and Marcus V. Tres. 2024. "Neotropical Biodiversity as Microbial Frontline for Obtaining Bioactive Compounds with Potential Insecticidal Action" Processes 12, no. 8: 1722. https://doi.org/10.3390/pr12081722
APA StyleSantos, M. S. N., Ody, L. P., Kerber, B. D., Castro, I. A., de Villa, B., Ugalde, G. A., Guedes, J. V. C., Mazutti, M. A., Zabot, G. L., & Tres, M. V. (2024). Neotropical Biodiversity as Microbial Frontline for Obtaining Bioactive Compounds with Potential Insecticidal Action. Processes, 12(8), 1722. https://doi.org/10.3390/pr12081722

